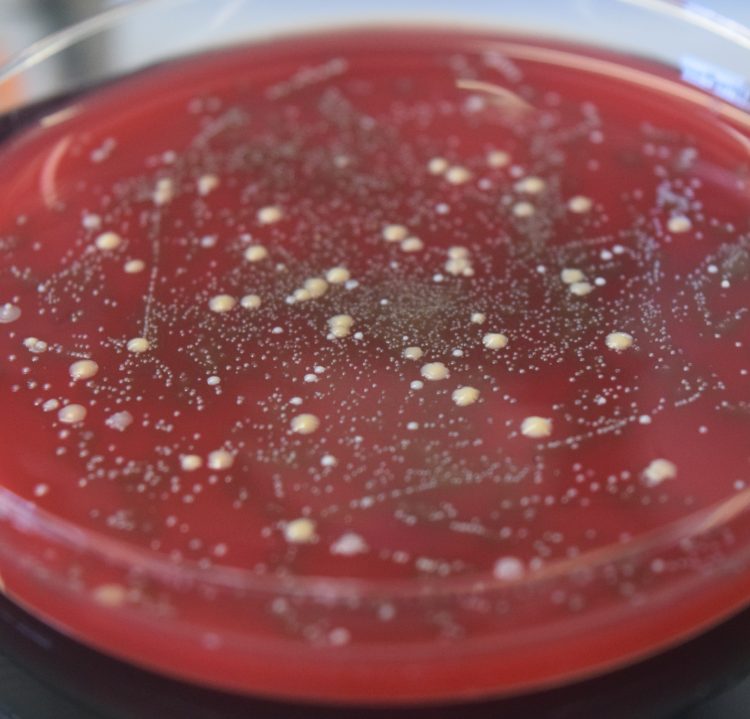

¡Hola mundo!
Soy Ciencia Miúda y quiero intentar convenceros de que las bacterias molan.
¿Por qué el nombre de Ciencia Miúda?
Por varias razones. Me explico. Miúda es una palabra galega que significa pequeña y yo soy la tercera de tres hermanas, así que siempre fui, soy y seré la pequeña. Además, soy microbióloga así que trabajo con los organismos más pequeños que hay. Por último (pero no por ello menos importante) con el nombre quería hacerle un guiño a la Small Science que es la investigación y la difusión de la ciencia y la tecnología llevadas a cabo por personas o grupos pequeños en la que los recursos humanos juegan un papel fundamental.
